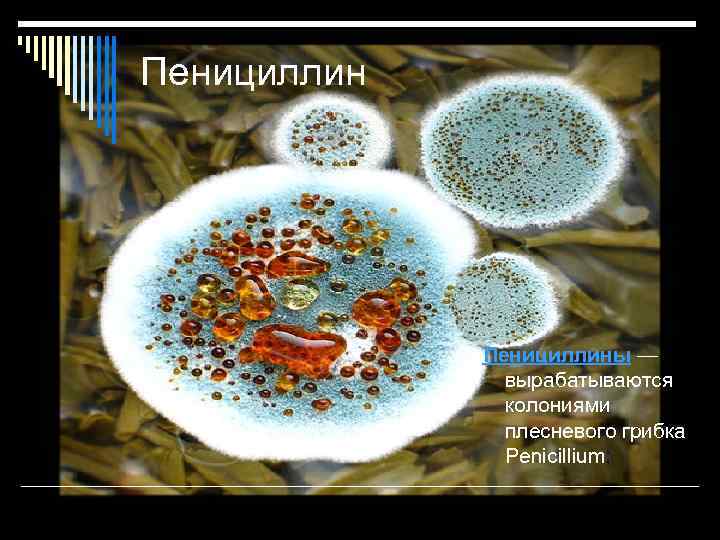
Пенициллины — вырабатываются колониями плесневого грибка Penicillium;

Антибиотики

Антибио тики (от др. -греч. ἀντί — anti — против, βίος — bios — жизнь) — вещества природного или полусинтетического происхождения, подавляющие рост живых клеток, чаще всего прокариотических или простейших

Используются Антибиотики используются для предотвращения и лечения воспалительных процессов, вызванных бактериальной микрофлорой. По влиянию на бактериальные организмы различают бактерицидные (убивающие бактерий, например, за счёт разрушения их внешней мембраны) и бактериостатические (угнетающие размножение микроорганизма) антибиотики

По спектру противомикробного действия антибиотики делятся 1. Антибиотики, действующие преимущественно на грамположительные микроорганизмы. К этой группе относятся пенициллин, эритромицин, линкомицин. 2. Антибиотики широкого спектра действия, то есть действующие на грамположительную и грамотрицательную микрофлору. Тетрациклины, аминогликозиды и другие. 3. Противогрибковые антибиотики: нистатин, гризеофульвин, леворин.

Побочные действия антибиотиков и химиопрепаратов, в основном, сводятся к аллергическим, токсическим реакциям или зависят от побочного химиотерапевтического эффекта: реакция бактериолиза, дисбактериоз, суперинфекции и др.
Пенициллины — вырабатываются колониями плесневого грибка Penicillium;

Противомикробное действие и бактерицидный эффект пенициллинов объясняют их способностью нарушать биосинтез клеточной стенки микроорганизмов. Применяется при стрептококках, пневмоккоках, менингококках, гонококках, а так же возбудителей особо опасных инфекций – сибирской язвы, дифтерии, столбняка, газовой гангрены и сифилиса. Предназначен только для парентерального введения (разрушается хлористоводородной кислотой желудка).

Побочный эффект аллергическая реакция, которая проявляется в виде кожных высыпаний, отека гортани и повышения температуры.

Препараты бензилпенициллина Короткого действ ия Длительного действия Полусинтет ические пеницил лины Натриевая соль Новокаиновая соль Ампицилли н Калиевая соль Бициллин-1 Оксациллин Бициллин-5 Карбеницил лин Бициллин-3 Карфецилли н

Аминогликозиды — обладают высокой токсичностью. Используются для лечения тяжелых инфекций типа заражения крови или перитонитов

Аминогликозиды образуют необратимые ковалентные связи с белками 30 S-субъединицы бактериальных рибосом и нарушают биосинтез белков в рибосомах, вызывая разрыв потока генетической информации в клетке. Гентамицин так же может воздействовать на синтез белка, нарушая функции 50 Sсубъединицы рибосомы.

Они оказывают бактерицидное и бактериостатическое действие на грамположительные и особенно грамотрицательные бактерии. Данная группа препаратов противопоказана при заболеваниях почек и людей со сниженным слухом. Побочный эффект ототоксичность, нефротоксическое действие. Препараты: неомицина сульфат, гентамицина сульфат.

Цефалоспориды Цефалоспорины — обладают схожей структурой с пенициллинами. Используются по отношению к пенициллинустойчи вым бактериям.

Механизм действия цефалоспоринов связывают с их способностью повреждать клеточные мембраны микроорганизмов, находящихся в стадии размножения. Кроме того, они нарушают активность ферментов клеточных мембран, что также способствует их разрушению и гибели микроба.

Цефалоспорины применяют при острых и хронических заболеваниях органов дыхания, инфекциях мягких тканей, перитоните, сепсисе, эндокардите, сифилисе, заболеваниях, вызванных кишечной палочкой, протеем, диплококками. Побочный эффекты нефротоксическое действие, псевдомембранозный колит. Препараты: цефалоридин, цефалексин, цефуроксим, цефотаксим.

Макролиды — антибиотики со сложной циклической структурой. Действие — бактериостатическое.

По спектру действия близки к пенициллину. Применяются при стафилококках, стрептококках, пневмококах, гонококках, возбудителей сифилиса, дифтерии, бруцеллеза, трахомы. А так жеиспользуется при лечение пневмонии, плеврите, рожистом воспалении, маситах, остеомиелитах, гнойного воспаления среднего уха, придаточных пазух носа, желче- и моче- выводящих путей, гонореи, бруцеллезах. Данная группа препаратов противопоказана при нарушениях функций печени. Хорошо всасывается через ЖКТ. Действует 4 -6 часов.

Побочные эффект боли в животе, тошнота, снижение аппетита, неспецифическая диарея, другие диспептические расстройства. Препараты: эритромицин, эритромицин фосфат, эритромициновая мазь, олеандомицина фосфат.